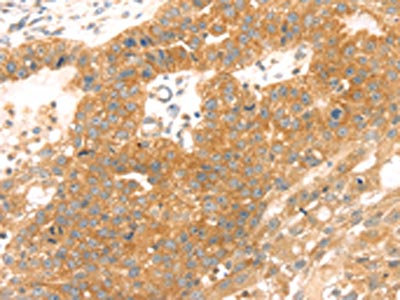

TMEFF2 Antibody
-
中文名稱:TMEFF2兔多克隆抗體
-
貨號:CSB-PA928507
-
規(guī)格:¥1100
-
圖片:
-
其他:
產(chǎn)品詳情
-
Uniprot No.:
-
基因名:
-
別名:Cancer/testis antigen family 120 member 2 antibody; CT120.2 antibody; HPP 1 antibody; HPP1 antibody; Hyperplastic polyposis protein 1 antibody; TEFF 2 antibody; TEFF2 antibody; TEFF2_HUMAN antibody; TENB 2 antibody; TENB2 antibody; TMEFF2 antibody; Tomoregulin antibody; Tomoregulin-2 antibody; TPEF antibody; TR 2 antibody; TR antibody; TR-2 antibody; Transmembrane protein containing epidermal growth factor and follistatin domains antibody; Transmembrane protein TENB2 antibody; Transmembrane protein with EGF like and two follistatin like domains 2 antibody; Transmembrane protein with EGF-like and two follistatin-like domains antibody
-
宿主:Rabbit
-
反應(yīng)種屬:Human,Mouse
-
免疫原:Synthetic peptide of Human TMEFF2
-
免疫原種屬:Homo sapiens (Human)
-
標(biāo)記方式:Non-conjugated
-
抗體亞型:IgG
-
純化方式:Antigen affinity purification
-
濃度:It differs from different batches. Please contact us to confirm it.
-
保存緩沖液:-20°C, pH7.4 PBS, 0.05% NaN3, 40% Glycerol
-
產(chǎn)品提供形式:Liquid
-
應(yīng)用范圍:ELISA,IHC
-
推薦稀釋比:
Application Recommended Dilution ELISA 1:2000-1:5000 IHC 1:25-1:100 -
Protocols:
-
儲存條件:Upon receipt, store at -20°C or -80°C. Avoid repeated freeze.
-
貨期:Basically, we can dispatch the products out in 1-3 working days after receiving your orders. Delivery time maybe differs from different purchasing way or location, please kindly consult your local distributors for specific delivery time.
-
用途:For Research Use Only. Not for use in diagnostic or therapeutic procedures.
相關(guān)產(chǎn)品
靶點詳情
-
功能:May be a survival factor for hippocampal and mesencephalic neurons. The shedded form up-regulates cancer cell proliferation, probably by promoting ERK1/2 phosphorylation.
-
基因功能參考文獻(xiàn):
- Differential TMEFF2 processing from a single transmembrane protein may be a general mechanism to modulate transmembrane protein levels and domains, dependent on the repertoire of ADAMs or TTSPs expressed by the target cell. PMID: 28762604
- TMEFF2 methylation is associated with clear cell renal cell carcinoma. PMID: 28128743
- Results suggest that TMEFF2 is a brain-enriched endogenous modulator of Abeta neurotoxicity and an enhancer of alpha-secretase processing of AbetaPP PMID: 26402097
- TMEFF2 regulates the non-canonical activin/BMP4 signaling, PI3K, and Ras/ERK1/2 pathways. PMID: 25573902
- c-Myc contributes to the epigenetic regulation of HPP1 via the dominant recruitment of HDAC3. PMID: 24919179
- TMEFF2 acts as a tumor suppressor in gastric cancer through direct interaction with SHP-1 and can be a potential biomarker of carcinogenesis. PMID: 24987055
- TMEFF2 and SARDH cooperate to modulate one-carbon metabolism and invasion of prostate cancer cells. PMID: 23824605
- Androgen signaling promotes eIF2alpha phosphorylation and subsequent translation of TMEFF2 via a mechanism that requires uORFs in the 5'-UTR of TMEFF2. PMID: 23405127
- Methylation of TMEFF2 gene is associated with colorectal neoplasia in ulcerative colitis and Crohn's colitis. PMID: 22532293
- Findings suggest that methylation-associated down-regulation of TMEFF2 gene may be involved in lung tumorigenesis and TMEFF2 methylation can serve as a specific blood-based biomarker for NSCLC. PMID: 22814847
- Several genes expressed at exceptionally high levels were identified associated with early oocyte development, TMEFF2, the Rho-GTPase-activating protein oligophrenin 1 (OPHN1) and the mitochondrial-encoded ATPase6 (ATP6). PMID: 22238370
- TMEFF2 can function to regulate PDGF signaling; it is hypermethylated and downregulated in glioma and several other cancers PMID: 21559523
- the tumor suppressor activity of TMEFF2 requires the cytoplasmic/transmembrane portion of the protein and correlates with its ability to bind to SARDH and to modulate the level of sarcosine. PMID: 21393249
- GDF15, HSPA2, TMEFF2, and VIM were identified as epigenetic biomarkers for Bladder cancer. PMID: 20975101
- Hypermethylation of HPP1 is associated with hMLH1 hypermethylation in gastric adenocarcinomas. PMID: 12384516
- Aberrant methylation of the HPP1 gene is a relative common early event in ulcerative colitis-associated colorectal carcinoma. PMID: 12460892
- inverse correlation between TMEFF2 and c-Myc expression PMID: 12729735
- Hypermethylation of p16, RUNX3, and HPP1 in Barreett exophagus may represent independent risk factors for the progression of Barrett esophagus to esophageal cancer. PMID: 15824739
- A secreted form of TMEFF2 is expressed from TMEFF2 locus and may functionally interact with full-length TMEFF2, or its binding partners, and may also influence current immune-based treatment strategies PMID: 16439095
- Hypermethylation of HPP1 is associated with primary adenocarcinomas of the small bowel PMID: 16619216
- Methylation testing of fecal DNA using a panel of epigenetic markers (methylated SFRP2, HPP1 and MGMT) may be a simple and promising non-invasive screening method for colorectal carcinoma and precancerous lesions. PMID: 17352030
- TMEFF2 contributes to cell proliferation in an ADAM17-dependent autocrine fashion in cells expressing this protein PMID: 17942404
- data provides evidence to support the role of HPP1 as a tumor suppressor gene; activation of the STAT1 pathway likely represents the principal mediator of HPP1's tumor suppressive properties PMID: 18059030
- Methylated PAX6- or TPEF-promoters could represent biomarkers for bladder cancer. PMID: 18070176
- Distinct TPEF/HPP1 (transmembrane protein containing epidermal growth factor) gene methylation patterns in gastric cancer indicate a field effect in gastric carcinogenesis. PMID: 18799374
- promoter of TPEF gene is frequently hpermethylated, and associated with loss of TPEF mRNA expression in esophageal squamous cell carcinoma PMID: 19040536
- Methylation of CLDN6, FBN2, RBP1, RBP4, TFPI2, and TMEFF2 in esophageal squamous cell carcinoma. PMID: 19288010
- Analysis of DNA from peripheral blood revealed that TPEF methylation was detectable in colorectal tumor patients and patients with early or pre-neoplastic lesions, but not in healthy volunteers. PMID: 15068392
顯示更多
收起更多
-
亞細(xì)胞定位:[Isoform 1]: Membrane; Single-pass type I membrane protein.; [Isoform 2]: Membrane; Single-pass type I membrane protein.; [Isoform 3]: Secreted.
-
蛋白家族:Tomoregulin family
-
組織特異性:Highly expressed in adult and fetal brain, spinal cord and prostate. Expressed in all brain regions except the pituitary gland, with highest levels in amygdala and corpus callosum. Expressed in the pericryptal myofibroblasts and other stromal cells of nor
-
數(shù)據(jù)庫鏈接:
Most popular with customers
-
-
YWHAB Recombinant Monoclonal Antibody
Applications: ELISA, WB, IHC, IF, FC
Species Reactivity: Human, Mouse, Rat
-
Phospho-YAP1 (S127) Recombinant Monoclonal Antibody
Applications: ELISA, WB, IHC
Species Reactivity: Human
-
-
-
-
-